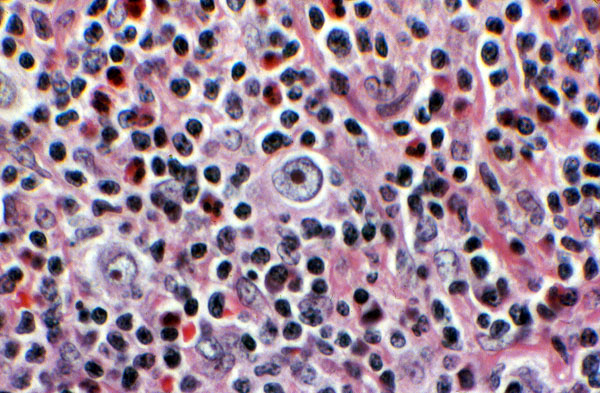

Mononuclear variant, Reed-Sternberg cell, mixed cellularity Hodgkin disease
Click picture to enlarge. Close window to return
This cell has only one nucleus, and is termed a mononuclear variant Reed-Sternberg cell. Note the background cellular constituents, which include benign lymphocytes, eosinophils and plasma cells.